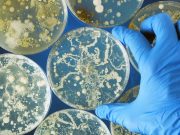
2019 to 2023 Saw Increase in NDM-Carbapenem-Resistant Enterobacterales

Kroger Recalls Pasta Salads Sold in 30 States for Listeria Risk
The recall includes Basil Pesto Bowtie Salad and Smoked Mozzarella Penne Salad
Second COVID Infection in Children Doubles Risk for Long COVID
Heightened risk seen for many conditions, including myocarditis, blood clots, kidney damage, abnormal heart rhythms, headache, and fatigue
HPV Vaccine Effective, Offers Herd Protection After 17 Years
Positivity decreased for 2vHPV, 4vHPV, and 9vHPV for vaccinated and unvaccinated participants from 2006 to 2023
CDC Leaves COVID Vaccination Up to Patients
Medical organizations still recommend vaccinations for pregnant women, children and those at high risk
Interim CDC Chief Calls for Separate MMR Shots
Health officials warn that separating the shots could delay vaccinations
Flu Vaccine Uptake Consistently Highest for Asian Patients, Lowest for Black Patients
Findings seen across flu seasons and age groups
2019 to 2023 Saw Increase in NDM-Carbapenem-Resistant Enterobacterales
Age-adjusted incidence of CP-CRE increased 69 percent and incidence of NDM-CRE increased 461 percent
Nearly 100 Sickened Aboard Royal Caribbean Ship With Norovirus
Norovirus outbreaks are common on cruise ships and often begin when a single infected person boards the vessel
Minnesota Confirms 10 New Measles Cases, All in Unvaccinated Travelers
The U.S. has reported 1,544 cases total, the most since 1992, with three deaths in Texas
Report Highlights Pediatric Influenza-Associated Encephalopathy in 2024-2025 Season
109 cases of IAE described, of which 34 percent were acute necrotizing encephalopathy and 66 percent were other IAEs